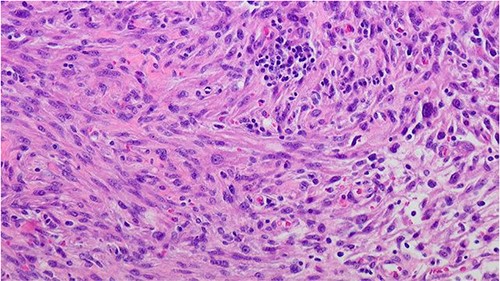

-
PDF
- Split View
-
Views
-
Cite
Cite
Abdul Baseet Arham, Robert A Robinson, Mohammed Abou Chakra, Michael A O’Donnell, Leiomyosarcoma of the prostate: a novel approach to treatment—case report and review of the literature, Journal of Surgical Case Reports, Volume 2024, Issue 3, March 2024, rjae138, https://doi.org/10.1093/jscr/rjae138
Close - Share Icon Share
Abstract
Leiomyosarcoma of the prostate is a rare and aggressive tumor, with a quarter of the patients harboring metastatic disease, commonly in the lung. It usually presents with urinary obstruction in a relatively younger patient group. A 29-year-old male presented with lower urinary tract symptoms to the urologist. Computed tomography scan revealed a large pelvic mass involving the prostate. Biopsy on two occasions yielded leiomyoma. Instead of conventional radical surgery, en-bloc resection of the mass was done while preserving the remaining portion of the prostate, seminal vesicles, and ejaculatory duct. Histopathology revealed a high-grade leiomyosarcoma with negative margins. The patient had excellent recovery of defecation, erectile, and ejaculatory functions within 2 months after adjuvant radiotherapy. At the 24-month follow-up there was no evidence of disease. En-bloc resection of the tumor can be considered in select cases to improve functional outcomes and sustain a higher quality of life in patients.
Introduction
Leiomyosarcoma of the prostate is a rare mesenchymal tumor which is difficult to diagnose. To date <200 case reports have been published in the literature [1]. Our case offers a novel insight into this rare disease both in terms of diagnostic difficulty, radiological appearance, management, and outcomes.
Case report
A 29-year-old male patient presented to the urologist with lower urinary tract symptoms (incomplete bladder emptying) over the last several years. He had no recent history of dysuria, hematuria, incontinence, weight loss, or bone pain. Findings on the computed tomography (CT)-urogram showed a pelvic mass arising inferior to the urinary bladder, which was 13.4 × 10.6 × 13.0 cm thick-walled, cystic, with solid-enhancing mural nodules. No evidence of any lymphadenopathy or metastasis was seen. He was prescribed tamsulosin for his urinary complaints and referred to the UIHC. An ultrasound-guided needle biopsy of the pelvic mass revealed leiomyoma of the prostate. It had bland smooth muscle cells with no cytologic atypia, no necrosis and mitotic activity <1/50 high power fields. Active surveillance with a 3-month follow-up CT was recommended.
The patient presented to the ED 3 months later with urinary retention and pain; this was relieved with catheterization. A CT scan revealed that his tumor had slightly increased in size (Fig. 1). He had an AUA symptom index of 35. Due to the refractory nature of his obstructive symptoms, he was scheduled for a TURP 2 weeks later, which again revealed leiomyoma. He was kept on interval follow-up for the next 2 years. During that time his PSA was 1.13 ng/ml. Magnetic resonance imaging (MRI) pelvis 2 years later showed the mass appeared to communicate with the posterior bladder neck (Fig. 2). His baseline renal function kept worsening (Creatinine 1.4 mg/dl); at that time, the patient was counseled regarding his treatment options, and he opted for surgery which he was told may require the removal of the prostate with loss of ejaculatory and/or erectile function.

Contrast CT pelvis (May 2020) showing stable complex solid and cystic pelvic mass abutting displacing the bladder superiorly and the prostate laterally.

MRI Pelvis (contrast) June 2021: well-marginated complex solid, cystic, and septated pelvic mass with multiple sites of enhancement and restricted diffusion; the mass appears to communicate with the bladder neck.
The mass was excised in its entirety with primary repair of the bladder neck/proximal urethral defect. Only the proximal-most one-third of the prostate was excised, and the distal two-thirds was left in situ. The right bladder, left seminal vesicle, prostatic pedicle, and neurovascular bundle were preserved. The left ureter was reimplanted.
In contrast to the prior biopsies, the resection specimen revealed the tumor harbored areas with marked nuclear atypia, high cellularity, mitoses, and necrosis. A diagnosis of poorly differentiated leiomyosarcoma was rendered, with margins free of tumor (closest was 2 mm) (Fig. 3). The patient had an uneventful recovery. He reported complete resolution of his obstructive symptoms 1 month after the procedure. Given his recent diagnosis of high-grade cancer, adjuvant conventional fractionation radiotherapy targeting the postoperative bed without any elective nodal coverage was undertaken. Two months after radiotherapy, he reported having a normal urinary stream, good erections with penetration and forward ejaculation. He has now been on follow-up for the past 24 months with six monthly CT scans with no evidence of recurrence (Fig 4).
Prostate leiomyosarcoma (high grade/poorly differentiated) 200×: the tumor shows marked nuclear atypia and pleomorphic nuclei.

Contrast CT pelvis at 20 months post-surgery showing no residual disease.
Discussion
Leiomyosarcomas are an uncommon group of prostate tumors, comprising only 0.1% of all primary prostate malignancies in adults [2]. Prostatic leiomyosarcomas typically affect men aged 40–78 years and most commonly present with urinary obstruction along with hematuria, pelvic pain, urinary frequency, and a mass effect on the gastrointestinal tract with resulting constipation and pain or burning during ejaculation [3].
The diagnosis of leiomyoma or leiomyosarcoma is usually made using a transrectal ultrasound guided needle biopsy or transurethral resection [4]. Our case demonstrated benign features on the initial core biopsies and TURP but both benign and high-grade components on the en bloc resected specimen, not unlike the case reported by Dinesh et al. [5] Separation of leiomyoma from leiomyosarcoma is often not difficult but sometimes very low grade leiomyosarcoma can mimic leiomyoma [6] (Table 1), immunohistochemistry is not very a reliable marker to differentiate in between them.
Various microscopic features used to differentiate leiomyomas from leiomyosarcomas.
| Tumor . | Cytologic nuclear Atypia . | Mitosis . | Necrosis . | References . |
|---|---|---|---|---|
| Leiomyoma | Absent | Scant | Absent | [6] |
| Atypical leiomyoma | Nuclear pleomorphism present | Absent | Absent | |
| Well-differentiated leiomyosarcoma | Mild | Present but not numerous | Usually absent | [3] |
| High grade/poorly differentiated leiomyosarcoma | Nuclear pleomorphism, diffuse atypia | High mitotic count | Common | [7] |
| Tumor . | Cytologic nuclear Atypia . | Mitosis . | Necrosis . | References . |
|---|---|---|---|---|
| Leiomyoma | Absent | Scant | Absent | [6] |
| Atypical leiomyoma | Nuclear pleomorphism present | Absent | Absent | |
| Well-differentiated leiomyosarcoma | Mild | Present but not numerous | Usually absent | [3] |
| High grade/poorly differentiated leiomyosarcoma | Nuclear pleomorphism, diffuse atypia | High mitotic count | Common | [7] |
Various microscopic features used to differentiate leiomyomas from leiomyosarcomas.
| Tumor . | Cytologic nuclear Atypia . | Mitosis . | Necrosis . | References . |
|---|---|---|---|---|
| Leiomyoma | Absent | Scant | Absent | [6] |
| Atypical leiomyoma | Nuclear pleomorphism present | Absent | Absent | |
| Well-differentiated leiomyosarcoma | Mild | Present but not numerous | Usually absent | [3] |
| High grade/poorly differentiated leiomyosarcoma | Nuclear pleomorphism, diffuse atypia | High mitotic count | Common | [7] |
| Tumor . | Cytologic nuclear Atypia . | Mitosis . | Necrosis . | References . |
|---|---|---|---|---|
| Leiomyoma | Absent | Scant | Absent | [6] |
| Atypical leiomyoma | Nuclear pleomorphism present | Absent | Absent | |
| Well-differentiated leiomyosarcoma | Mild | Present but not numerous | Usually absent | [3] |
| High grade/poorly differentiated leiomyosarcoma | Nuclear pleomorphism, diffuse atypia | High mitotic count | Common | [7] |
Other rare spindle cell tumors can also involve the prostate including inflammatory myofibroblastic tumor, rhabdomy-osarcoma, GIST, sarcomatoid carcinoma, STUMP, and prostatic stromal sarcoma [8]. In our case, prostatic stromal sarcoma was high on the pathology differential as these spindled neoplasms also show nuclear pleomorphism, necrosis, hypercellularity, and increased mitoses. However, these tumors are usually CD34 positive, while our case was CD34 negative [9].
On MRI leiomyosarcomas show a heterogeneously enhancing solid mass with poorly defined tumor margins and, depending on the stage, tumor infiltration into adjacent organs [10]. This classic presentation differs from our case, which initially presented as a well-capsulated mass with septation and multiple cysts. This is not dissimilar to how a prostatic cystadenoma may present as a large pelvic mass extending to the abdomen with multiple septations filled with simple fluids and solid components [11] or STUMP which may have partly cystic and partly solid components [10].
Leiomyosarcomas behave aggressively, with 25% of cases presenting with metastatic disease, the most common being the lung (17.6%); followed by the liver (11.7%) and bone (5.8%) [12]. Thus, treatment options depend on the grade and stage of the tumor at presentation with multimodal therapy (adjuvant and neoadjuvant therapy) being the superior option compared with surgery alone, leading to better survival outcomes [13]. An earlier paper published at MD Anderson demonstrated that high-grade stage III leiomyosarcomas with microscopically negative margins had mean survival of 88 months when treated with multimodal therapy compared with 39 months when treated with surgery alone [2]. Prognostic factors that determine better survival outcomes include the absence of metastasis (18-month median survival with metastasis) and positive surgical margins (5-year actuarial survival 0% vs. 67% if margins negative). Low-grade sarcoma and the size of the tumor did not have an effect on the overall survival [2].
Radical cystoprostatectomy, pelvic exenteration, etc. are the standard surgical procedures [14]; highly invasive surgeries which have a high degree of morbidity: with a reported 56% impotence rate following bilateral nerve sparing procedure [15]. Due to this patient’s young age and initial benign diagnosis, we did a prostate preserving surgery with only excision of the mass and affected fistulous region of the bladder. This yielded better functional outcomes compared with conventional radical cystoprostatectomy. Thus, this treatment approach could be further explored in future studies for younger patients where quality of life, including sexual function, is a significant concern.
Conclusion
Instead of conventional radical surgery, en bloc resection of the tumor coupled with multimodal therapy might be considered in select cases. This helps preserve the rectal, bladder, and ejaculatory functions resulting in sustaining a high quality of life for these patients. Further studies need to be conducted on the long-term oncologic outcomes of this procedure.
Conflict of interest statement
None declared.
Funding
None declared.